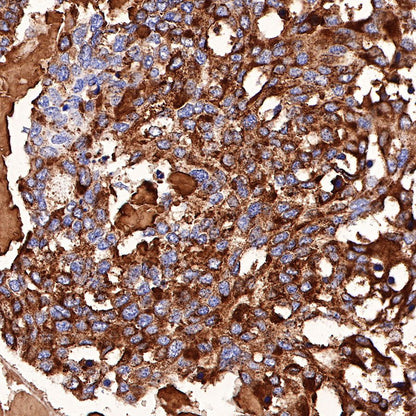

Product Specification
| Host |
Rabbit |
| Antigen |
Calcitonin (CT) |
| Synonyms |
CT |
| Immunogen |
Synthetic Peptide |
| Location |
Secreted |
| Accession |
P01258 |
| Clone Number |
SDT-204-72 |
| Antibody Type |
Rabbit mAb |
| Application |
WB, IHC-P, ICC |
| Reactivity |
Hu |
| Purification |
Protein A |
| Concentration |
0.25 mg/ml |
| Physical Appearance |
Liquid |
| Storage Buffer |
PBS, 40% Glycerol, 0.05% BSA, 0.03% Proclin 300 |
| Stability & Storage |
12 months from date of receipt / reconstitution, -20 °C as supplied |
Dilution
| application |
dilution |
species |
| IHC-P |
1:1000 |
|
| WB |
1:500 |
|
| ICC |
1:250 |
|
Background
Calcitonin is a hormone that is produced in humans by the parafollicular cells (commonly known as C-cells) of the thyroid gland. It is found in the thyroid of chordates and humans and the endostyle of invertebrates. Calcitonin is involved in helping to regulate levels of calcium and phosphate in the blood, opposing the action of parathyroid hormone.